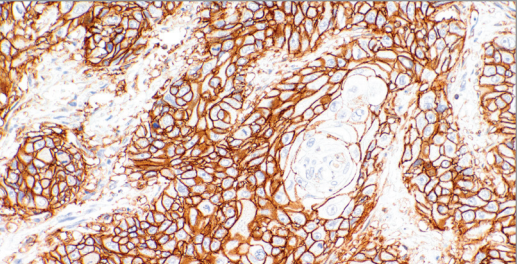

CD44 Rabbit Monoclonal Antibody(ARM950)
CAT.NO. : ARM6740
RMB Please choose
RMB Please choose
Size:
Trail, Bulk size or Custom requests Please contact us
*产品价格可能会有所调整,请以品牌方官网实时更新的价格为准,以确保准确性。
Background
Cluster of Differentiation 44 (CD44) is a glycoprotein receptor for hyaluronic acid that plays a fundamental role in cellular adhesion, stromal binding, migration, and cell-cell interactions. Positive staining with Anti-CD44 is implicated in a multitude of different cancer types, including breast, prostatic, renal cell, colonic, hepatocellular, and genitourinary carcinomas, as well as non-Hodgkin's Lymphoma, metastatic melanoma, gastric cancer, and some soft tissue tumours. It has also been demonstrated that there is a positive correlation between tumour progression and increased expression of CD44v, a high molecular weight CD44 isoform that has been described in epithelial cells. Given the expression of CD44 in a wide range of cancers, the most practical application of CD44 immunostaining is its use in discriminating between urothelial transitional cell carcinoma in situ from non-neoplastic changes in the urothelium.
Application
|
Application |
Dilution Ratio |
|
IHC |
1:50 - 1:200 |
Overview
|
Molecular Weight |
15,635 Da |
|
3D Structure |
ModBase 3D Structure for P16070 |
|
Isotype |
IgG |
|
Host |
Rabbit |
|
Species Reactivity |
Human |
|
Purity/Purification |
Purified |
|
Form/Format |
Tris Buffer, pH 7.3 - 7.7, with 1% BSA and <0.1% Sodium Azide |
|
Immunogen |
Recombinant Protein |
Data
Immunohistochemical staining of human esophagus tissue using CD44 Rabbit Monoclonal Antibody (ARM950).
Storage
Store at 4°C short term. For long term storage, store at -20°C, avoiding freeze/thaw cycles.
Research Use Only
For Research Use Only. Not for use in diagnostic procedures.
New Products
